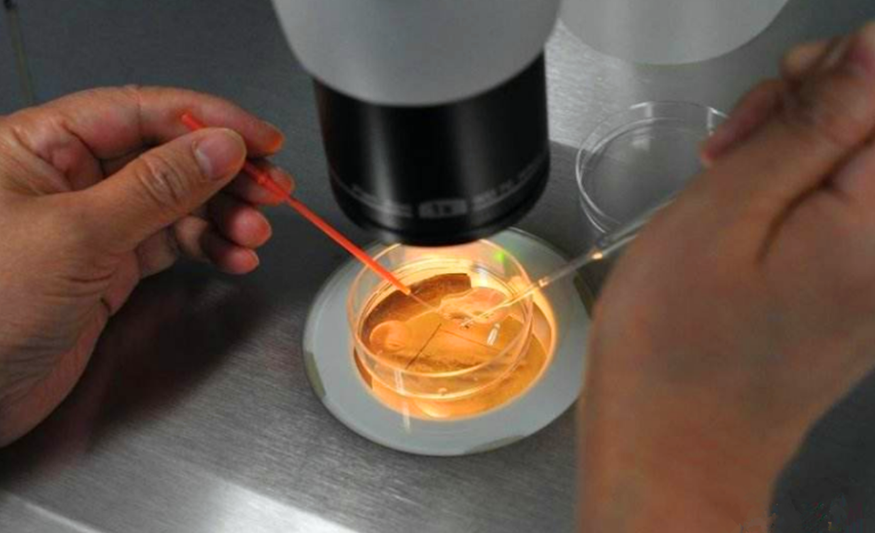

您的位置:美国试管机构 > 试管百科 > 试管资讯 >
试管婴儿中胚胎实验室的包办婚姻和“拆蛋专家”!
思普乐海外 2025-10-21 08:13 人气:
在试管婴儿的助孕过程中,有很多生动形象技术用语,比如说“打孔”、“激活”、“拆蛋”等等。“拆蛋”只是我们平时较为通俗易懂的叫法,专业术语是“卵母细胞脱颗粒细胞”。

一、什么是“拆蛋”?
将来受精后发育成胚胎的卵子如同“蛋黄”;而卵子周围的颗粒细胞如同“蛋清”。
为卵子的发育提供水分及营养物质,包裹卵泡的膜细胞如同“蛋壳”相当于是卵子的羽林军时刻保护的卵子;简而言之,体外受精中,精子要靠近卵子必须要克服一系列障碍,其中最主要的第一道屏障就是颗粒细胞。
拆蛋就是“剥鸡蛋,取蛋黄”的过程。
拆蛋”后的卵子,就像是剥壳鸡蛋那样,又光又滑!
二、为什么要“拆蛋”?
在试管婴儿技术中,“拆蛋”是为了方便观察受精以及胚胎发育的一项常规操作。只有将卵子暴露出来,才能更准确地判断是否成熟、形态是否正常、是否受精,更清晰地观察胚胎的发育情况。
此外,在“二代试管技术(ICSI)”的操作中,需要在取卵后2小时左右,对卵胞浆内注射精子之前,拆蛋去除卵子周围的颗粒细胞,这样才能清楚选择注射位置,以及观察精子是否成功注射入卵子。
在“一代试管”中,等授精后4-6小时拆蛋,观察是否卵子已经受精,如果没有受精,就做补救的ICSI。
三、怎么“拆蛋”呢?
“拆蛋”通常用酶消化法或机械法来将包围卵子的颗粒细胞去除,从而使卵母细胞“暴露”。
酶消化主要用于第二代试管婴儿技术。在取卵至少半小时后,把卵子移入消化酶中,先用“化学方法”让颗粒细胞松散脱落,再用不同口径的剥卵针温柔地反复吹打,直至完全去除颗粒细胞。机械法一般用在第一代试管婴儿,授精后用剥卵针以“物理方法”通过机械性的轻轻吹打,将卵子释放出来。
“拆蛋”是一项精细活,需要使用剥卵管反复小心吹打。
一方面,需要将卵剥得干净,方便观察受精情况。
另一方面,需要尽量减少对卵子的机械挤压,以免造成卵子内在损伤。

四、“拆蛋”会不会损伤卵子呢?
“拆蛋”的过程是个技术活,只要操作得当,并不会损伤卵子。
研究结果显示,“拆蛋”脱颗粒细胞的操作不仅是安全的,而且可以帮助消除对部分IVF不受精的疑虑,可以尽早地发现受精失败的可能,适时进行ICSI补救,改善IVF助孕的结局。
胚胎师们是在高倍显微镜下对卵子进行精细的脱颗粒细胞操作,他们的手经过长期训练,动作轻柔而准确,绝不会伤害到卵细胞。再加上严格的拆蛋时间的把握,和常年的工作经验累积,“拆蛋”早已是一名合格的胚胎师的基本功。
五、精液取出后在胚胎室发生了什么?
精液标本的处理过程是对精子筛选淘汰和“优选”的过程,试管婴儿治疗过程中,获取足够数量“优秀”的活动精子至关重要。精液处理可以去除精浆、杂质,并使精子获能,最终优选活力四射,长像俊美的精子去和卵子妹妹约会。精液优化处理的方法有很多种,临床上常用的主要包括密度梯度离心法、直接上游法、简单洗涤法等,不同方法适用不同人群和精子计数。
一、密度梯度离心法:适用于正常精液、精浆粘稠度高的精液。该方法精子的回收率高,结果稳定,有利于标准化,而且明显增加精子活力。将精液放置在不同密度梯度培养液的上方,分别是80%和40%的梯度液,离心后分选精子,活动精子能穿过梯度液在离心管底形成一个松软的沉淀团,便可以得到活力最强的那一群精子。
二、直接上游法:适用于正常精液。其回收精子质量较高,操作简便,但回收率相对较低,不适用处理精子活力低,精液粘稠度高或者液化不良的精液标本。操作是将液化的精液加入试管底部,加上培养液,利用精子有向上游到培养液面的运动能力,从表面收集到活力最强的精子。
三、直接洗涤法:适用于精子浓度极低、活力低的精液标本,或附睾及睾丸穿刺得到的精子。用精子洗涤液和精液充分混匀后直接离心,尽可能多的回收精子。
最后挑选单个精子注射到卵子妹妹体内完成受精。下面的道路就是卵子和精子共同的结晶,胚胎的成长道路了,然后嘛,期待那个健康可爱的宝宝呀。